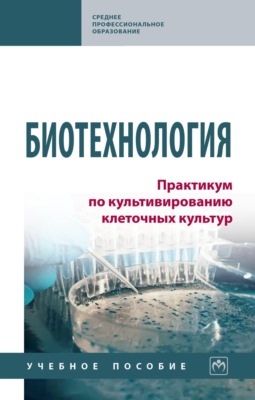
Биотехнология. Практикум по культивированию клеточных культур

Вадим Николаевич Гуреев
Wyślemy powiadomienie o nowych książkach, audiobookach, podcastach
Wszystkie książki autora
Wszystkie książki
Wszystkie książki
Książki tekstowe
3Książki Вадим Николаевич Гуреев można pobrać w formatach fb2, txt, epub, pdf lub czytać online.
Zaloguj się, aby dodać recenzję